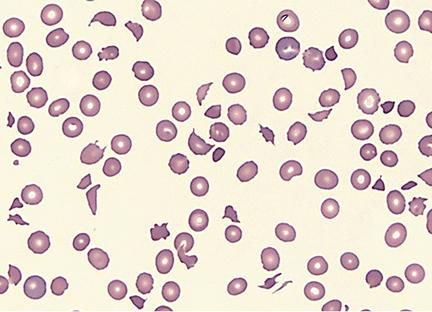
Image for question 23

A 76-year-old man is admitted to the hospital for evaluation of sudden-onset chest pain. Three days after admission, he develops severe shortness of breath. Despite appropriate care, the patient dies. The heart at autopsy is shown. Which of the following most likely contributed to this patient's cause of death?

A 80-year-old woman is brought to the emergency department from a senior living home with a chief complaint of acute onset and severe abdominal pain with 5 episodes of bloody diarrhea. She has a history of having chronic constipation, and postprandial abdominal pain which subsides after taking nitroglycerin. The abdominal pain that she is currently experiencing did not subside using her medication. A week ago, she had a percutaneous intervention for an inferior wall STEMI. On physical examination, the patient looks pale and confused. The vital signs include: blood pressure 80/40 mm Hg, heart rate 108/min, respiratory rate 22/min, and temperature 35.6°C (96.0°F). The patient receives an aggressive treatment consisting of intravenous fluids and vasopressors, and she is transferred to the ICU. Despite all the necessary interventions, the patient dies. During the autopsy, a dark hemorrhagic appearance of the sigmoid colon is noted. What is the most likely pathology related to her death?
A 19-year-old Caucasian male collapsed from sudden cardiac arrest while playing in a college basketball game. Attempts at resuscitation were unsuccessful. Post-mortem pathologic and histologic examination found asymmetric left ventricular hypertrophy and myocardial disarray. Assuming this was an inherited condition, the relevant gene most likely affects which of the following structures?
A 32-year-old woman who recently emigrated to the USA from Japan comes to the physician because of a 3-month history of night sweats, malaise, and joint pain. During this time, she has also had a 6-kg (13-lb) weight loss. Physical examination shows weak brachial and radial pulses. There are tender subcutaneous nodules on both legs. Carotid bruits are heard on auscultation bilaterally. Laboratory studies show an erythrocyte sedimentation rate of 96 mm/h. A CT scan of the chest shows thickening and narrowing of the aortic arch. Microscopic examination of the aortic arch is most likely to show which of the following findings?
A 69-year-old man is brought to clinic by his daughter for poor memory. She states that over the past two years his memory has been slowly declining though he has been able to take care of himself, pay his own rent, and manage his finances. However, two months ago she noticed a sharp decline in his cognitive functioning as well as his gait. Then one month ago, she noticed a similar decline in his functioning again that came on suddenly. The patient has a past medical history of diabetes mellitus type II, hypertension, obesity, and dyslipidemia. Current medications include hydrochlorothiazide, lisinopril, metformin, and glipizide. His blood pressure is 165/95 mmHg, pulse is 82/minute, he is afebrile, and oxygen saturation is 98% on room air. Cardiac exam reveals a crescendo-decrescendo murmur heard in the left upper sternal border that radiates to the carotids. Abdominal exam is benign, and neurologic exam reveals an unsteady gait. Which of the following findings is associated with the most likely diagnosis?
A 58-year old man comes to the emergency department because of progressively worsening shortness of breath and fatigue for 3 days. During the last month, he has also noticed dark colored urine. One month ago, he underwent mechanical aortic valve replacement for high-grade aortic stenosis. A photomicrograph of a peripheral blood smear from the patient is shown. Which of the following findings is most likely to be seen in this patient?
An investigator is studying genetic mutations of coagulation factors from patient samples. Genetic sequencing of one patient's coagulation factors shows a DNA point mutation that substitutes guanine for adenine. The corresponding mRNA codon forms a glutamine in place of arginine on position 506 at the polypeptide cleavage site. This patient's disorder is most likely to cause which of the following?
A 31-year-old woman comes to the physician for evaluation of worsening pain, swelling, and erythema in her left leg for the past 4 hours. She returned from a trip to Taiwan to celebrate her sister's wedding 2 days ago. She has no history of serious illness. She is sexually active with one male partner and uses a combined oral contraceptive pill (OCP). She does not smoke, drink, or use illicit drugs. Her only other medication is a multivitamin. Her temperature is 37.2°C (99°F), pulse is 67/min, respirations are 16/min, and blood pressure is 90/60 mm Hg. Examination shows swelling in her left calf and pain behind her left knee when she is asked to dorsiflex her left foot. Laboratory results show elevated D-dimers. Which of the following is the most likely cause of this patient's clinical presentation?
A 3-year-old boy is brought to the emergency department after losing consciousness. His parents report that he collapsed and then had repetitive, twitching movements of the right side of his body that lasted approximately one minute. He recently started to walk with support. He speaks in bisyllables and has a vocabulary of almost 50 words. Examination shows a large purple-colored patch over the left cheek. One week later, he dies. Which of the following is the most likely finding on autopsy of the brain?
A 41-year-old man with a history of hypertension and hyperlipidemia is brought to the emergency department by his wife for difficulty breathing after choking on food at dinner. He is unconscious and pulseless on arrival. Despite appropriate life-saving measures, he dies. Examination of the heart shows a necrotic, pale yellow plaque in the left circumflex artery. Similar lesions are most likely to be found in which of the following locations?
Atherosclerosis
Practice Questions
Ischemic heart disease
Practice Questions
Myocardial infarction pathology
Practice Questions
Hypertensive heart disease
Practice Questions
Congenital heart defects
Practice Questions
Valvular heart disease
Practice Questions
Rheumatic heart disease
Practice Questions
Infective endocarditis
Practice Questions
Myocarditis and cardiomyopathies
Practice Questions
Pericardial diseases
Practice Questions
Aneurysms and dissections
Practice Questions
Vasculitis
Practice Questions
Cardiac tumors
Practice Questions
Get full access to all questions, explanations, and performance tracking.
Scan to download app
Enter your email to get your 85% OFF code and unlock the full USMLE question bank on the app.